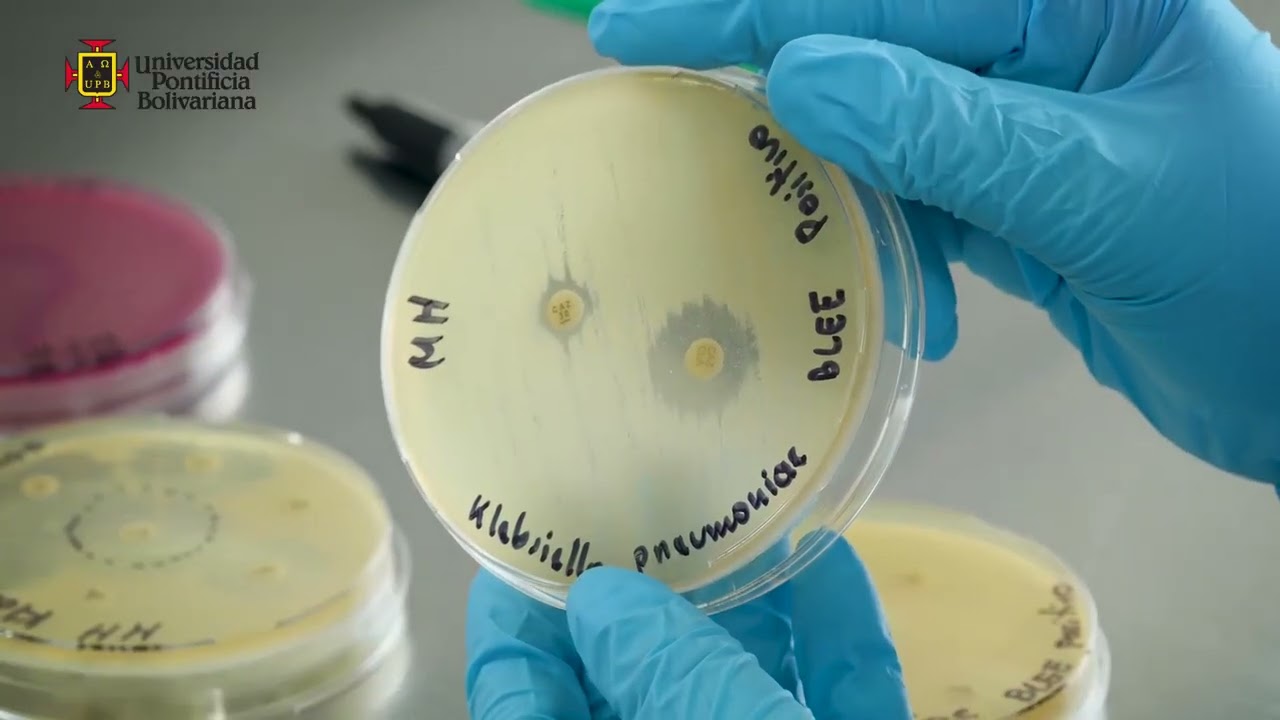
Mecanismos de resistencia de las bacterias y pruebas para su detección en el laboratorio

Mecanismos de resistencia de las bacterias y pruebas para su detección en el laboratorio
Автор: UPB Saludable
Загружено: 2022-03-02
Просмотров: 40443
Ingresa a nuestro sitio web:
https://www.upb.edu.co/es/upbvirtual
https://auladigital.upb.edu.co/Portaf...
https://www.upb.edu.co/es/home
Síguenos en las redes:
/ upbvirtual
/ upbvirtual
/ upbvirtual
/ upbcolombia
/ comunica. .
/ upbcolombia
/ upbcolombia
Доступные форматы для скачивания:
Скачать видео mp4
-
Информация по загрузке:



















